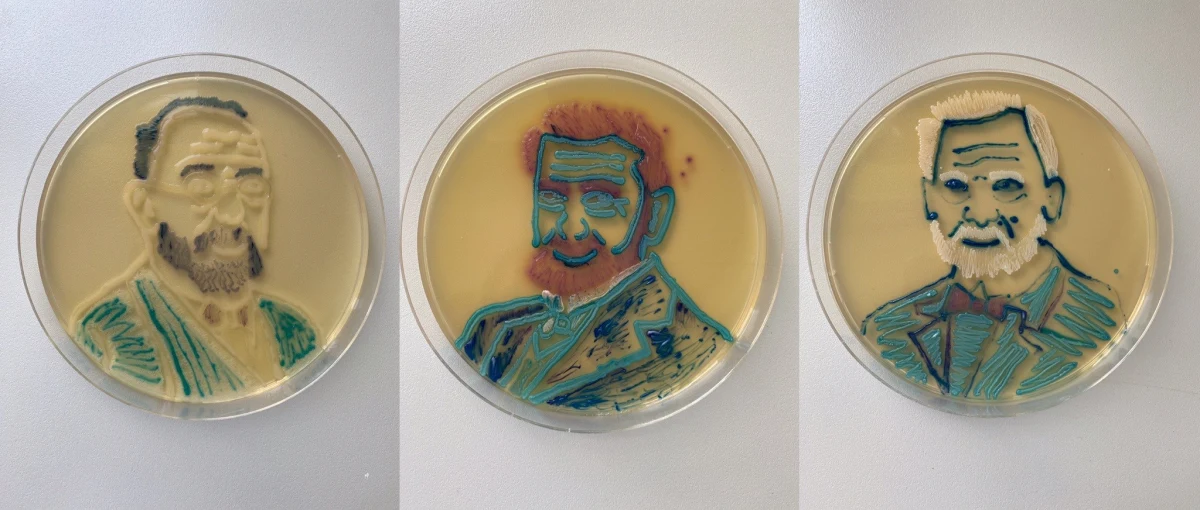
Martyna Pietrzak jest studentką trzeciego roku weterynarii na Uniwersytecie Przyrodniczym w Poznaniu. Jej dość nietypowym hobby jest malowanie mikrobiologiczne. Jako farb studentka używa mikrobów i bakterii.

Martyna Pietrzak jest studentką trzeciego roku weterynarii na Uniwersytecie Przyrodniczym w Poznaniu. Jej dość nietypowym hobby jest malowanie mikrobiologiczne. Jako farb studentka używa mikrobów i bakterii.
Studentka z Poznania tworzy sztukę za pomocą mikrobów i bakterii. Wykorzystuje do tego specjalistyczny sprzęt oraz mikroorganizmy, za pomocą których maluje portrety. Jak wygląda to w praktyce?
Mam swego rodzaju pędzel w postaci ezy. To taka igła z zaokrągloną końcówką - mówi w rozmowie z RMF FM Martyna Pietrzak. Pobieram bakterię i maluję nią na agarze, czyli takim specjalnym podłożu, które jest moim "płótnem" - dodaje studentka.
Malowanie bakteriami jest trudną sztuką, wymagającą dużych nakładów cierpliwości. Jak wyjaśnia studentka, bakterie trzeba odpowiednio dobrać. Każda z nich wydziela inny kolor oraz w różny sposób oddziałuje na nie temperatura.
Malarz widzi to co maluje, a ja tworzę najpierw niewidzialny obraz. Wybieram bakterie, rozsmarowuje, potem wkładam do takiego naszego piekarnika i sprawdzam co z tego wyszło. Czasem występuje niepożądany efekt. Kolor jest za słaby, za mocny lub bakteria pod wpływem temperatury tak się rozrośnie, że cała praca nie nadaje się do pokazania - wyjaśnia w rozmowie z dziennikarzem RMF FM, Beniaminem Piłatem.
Studentka zakwalifikowała się do specjalistycznego konkursu Agar Art organizowanego przez Amerykańskie Towarzystwo Mikrobiologiczne. Konkurs Agar Art łączy naukę i sztukę. Artyści-naukowcy używają naturalnie kolorowych lub genetycznie zmodyfikowanych drobnoustrojów jako farby, a agaru bakteriologicznego jako płótna - czytamy w komunikacie przesłanym przez Uniwersytet Przyrodniczy w Poznaniu.
Martyna Pietrzak stworzyła portrety najwybitniejszych mikrobiologów: Roberta Kocha, Louisa Pasteura oraz Odo Bujwida, polskiego mikrobiologa, ucznia Kocha, a prywatnie ojca pierwszej kobiety lekarza weterynarii, Heleny Jurgielewiczowej. Portrety zostały namalowane różnymi gatunkami bakterii, których bank jest tworzony przez prof. UPP dr hab. Agnieszkę Pękalę-Safińską z Katedry Nauk Przedklinicznych i Chorób Zakaźnych Wydziału Medycyny Weterynaryjnej i Nauk o Zwierzętach UPP.